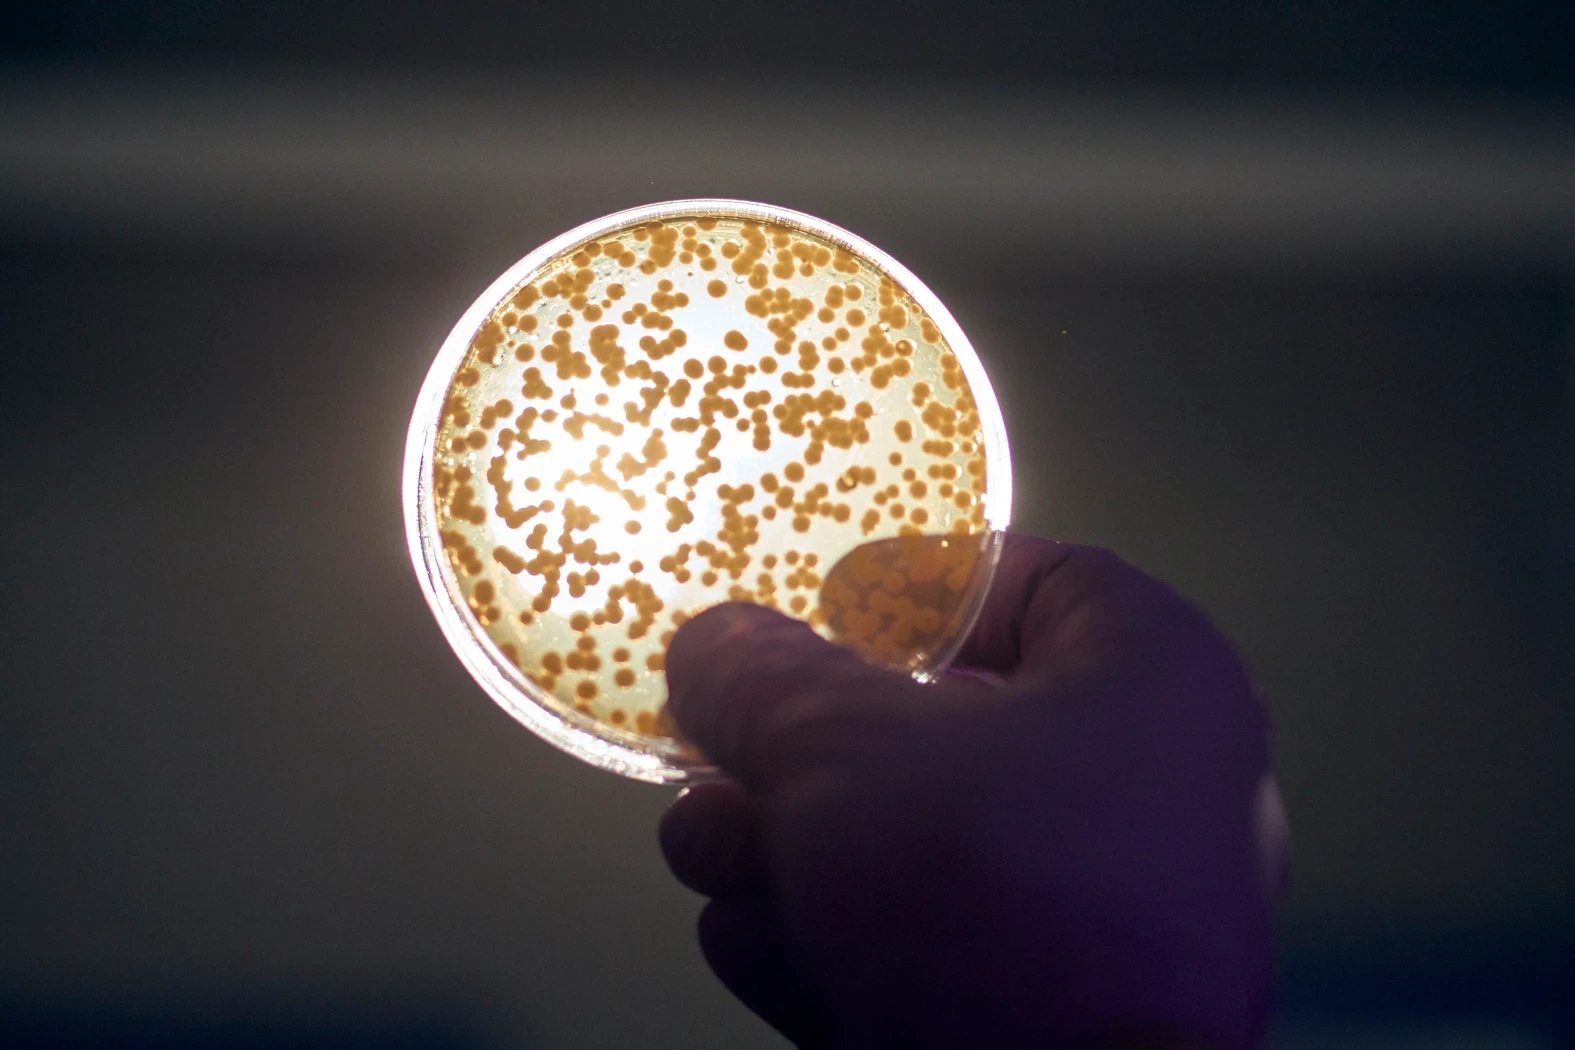
This Leather Jacket? It Came From a Petri Dish

To visit the vanguard of fashion, one must first manage to find Nutley, New Jersey, on a map; then, a short drive from Manhattan later, after a right turn onto Ideation Way and up the winding drive, one arrives at a hulking, 72,900-square-foot brutalist structure. Welcome to the production headquarters of Modern Meadow, a start-up that has been quietly—and under top secrecy—perfecting a proprietary bioengineered leather that could revolutionize the textile industry.
Late last year, after I managed to wrangle a heavily supervised visit to the lab, I held in my hands the result of their efforts. Delivered to me in a manila envelope, with a reiterated warning that I not take any photos, was a 12-inch-by-12-inch square of the first generation of Zoa, the company’s trademarked material. I was one of the first journalists allowed access to the substance—and much of the company’s plans for it remain shrouded in mystery. It would not disclose how it intends to use the material—what products it might create or brands it might partner with. What I do know is that Modern Meadow expects to go commercial in 2020—and industry insiders are betting it’ll be big. Among their top-tier investors is Tony Fadell, cofounder of Nest, inventor of the iPod, and co-inventor of the iPhone, as well as influential firms Iconiq, Horizon Ventures, and many others. Here’s what else I know: Zoa looked and felt exactly like leather. Only it wasn’t leather. The humble stretch of material—which I soon began gently stroking under the slightly nervous watch of the company’s chief technology officer, David Williamson—was brewed in a vat of bacteria upstairs in the fermentation lab.
. . .